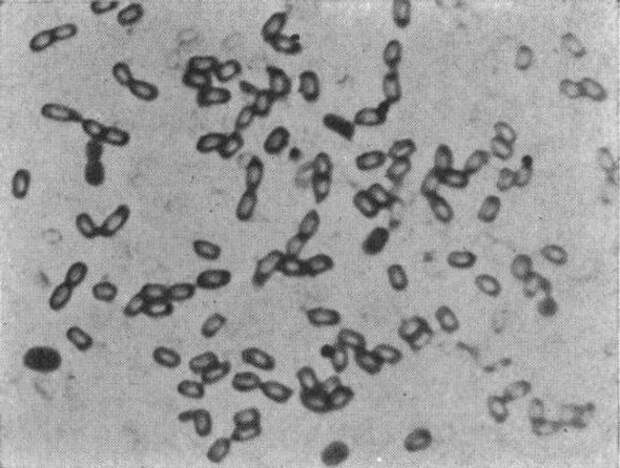

Author: Exuperist / Source: Neatorama
Bacteria has proven itself to be near indestructible much like cockroaches. But how indestructible are they? Well, Charles Lipman conducted experiments to see if bacteria could survive long periods of time so he looked for them in coal and began reanimating them.
Lipman did not believe that the bacteria he coaxed from coal were alive in the sense that the…
The post Microbes That Cheat Death appeared first on FeedBox.